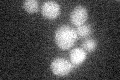
YDR113C
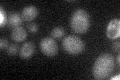
YDR113C

View description
Securin, inhibits anaphase by binding separin Esp1p; blocks cyclin destruction and mitotic exit, essential for meiotic progression and mitotic cell cycle arrest; localization is cell-cycle dependent and regulated by Cdc28p phosphorylation
Localization:
Intensity:
Fold change:
Significance:
-
C’ GFP library in SD
below threshold14.61 -
N' NOP1pr-GFP in SD

cytosol,nucleus40.2162 -
N' TEF2pr-mCherry in SD

missing0 -
N' NATIVEpr-GFP in SD

missing0 -
N' TEF2pr-VC and Cyto-VN in SD

#N/A0 -
C’ GFP library in SD+DTT

cytosol16.961.16No -
C’ GFP library in SD+H2O2

cytosol16.931.15No -
C’ GFP library in Starvation Media
cytosol23.551.61No -
C’ GFP library on the background of Pup2-DaMP

N/A -
C’ GFP library on the background of CCT mutant

N/A0N/AYes
